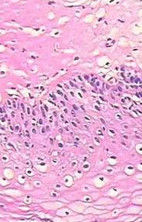
假性尖銳濕疣 假性尖銳濕疣

概述
假性尖銳濕疣,既是假性濕疣,診斷時宜慎重。此病為一良性乳頭瘤病,不屬於性傳播疾病,無傳染性,在20~30 歲婦女的小陰唇內側見多數1-2 mm光滑丘疹,群集但不互相融合,似魚子狀或小息肉狀,有時癢,可能由於生理變異或陰道白色念珠菌致使白帶增多刺激所致。本病不須治療。
假性尖銳濕疣症狀特徵
假性尖銳濕疣是一種至今發病原因不明的疾病,其臨床特點和組織病理與尖銳濕疣極易混淆。因此,臨床上甚易誤診。①色澤:假性尖銳濕疣外觀呈淡紅色(黏膜色)67例,淡褐色13例。
②大小:假性尖銳濕疣直徑1~2mm。
③行態:假性尖銳濕疣魚子狀66例,絨毛狀7例,息肉狀2例,丘疹狀3例,苔蘚狀1例,絲狀1例。
④部位:假性尖銳濕疣兩小陰唇內側46例,陰道前庭32例,單側小陰唇2例。
病發特點和治療
女性假性尖銳濕疣(絨毛狀小陰唇)的病因可能是生理性異常,也可能與其他感染有關,如念珠菌感染、泌尿系感染,與長期陰道分泌物刺激有關。假性尖銳濕疣主要症狀是外陰瘙癢,白帶多,皮膚損害限於小陰唇,為粟粒大小,黏膜色或淡紅色小丘疹,表面光滑如魚子狀,群集分布,好發在20~30歲的女性外陰,特別是小陰唇內測和陰道前庭。假性尖銳濕疣部分發生絨毛狀改變。醋酸白試驗陰性,甲苯胺藍試驗陰性。42例組織病理示黏膜上皮大片空泡樣細胞,但此細胞大小.形態.細胞極性及染色均正常,胞漿空泡圓而規則,而無診斷性空泡細胞可見。行PCR檢測20例人乳頭瘤病毒陰性。說明假性尖銳濕疣與人類乳頭狀瘤病毒無關。治療此病時主要應治療其他感染,若有念珠菌性陰道炎、滴蟲性陰道炎或泌尿系感染要首先予以治療,應加強預防,避免感染這類疾病。若沒有感染,就不會有外陰瘙癢的症狀,女性假性尖銳濕疣的皮損就會逐漸減少。因而對女性假性尖銳濕疣皮膚損害從醫療的角度來講,不需要特殊治療。假性尖銳濕疣的治療,一般還是不要處理的好。這是因為使用雷射消除掉這些增生物,也有可能還會長出來,而且用雷射的話,外陰傷口不容易保護,產生了疤痕更麻煩,所以,專家建議,對於假性濕疣還是不要處理的好。診斷
本病臨床表現與不典型尖銳濕疣極其相似,本組誤診率50%,誤診原因如下:認識不足
因此,不能將兩種疾病從臨床角度予以鑑別。初診時便武斷地診斷為尖銳濕疣而誤診。思維片面
將兩個以上性伴侶的患者,只要生殖器出現濕疣樣皮損,便輕易診斷為尖銳濕疣。依賴病理
因部分醫生對皮損形態認識不夠,故遇到生殖器皮疹便常規做組織活檢,靠病理科醫生定論。由於大部分病理醫生並非皮膚病專業,對假性尖銳濕疣損特徵掌握不夠,在閱片中單憑細胞空泡樣變,便診斷為尖銳濕疣,加之臨床醫生,尤其是婦產科和泌尿外科醫生過於依賴病理診斷,從而導致誤診。初步診斷
未做進一步檢查,本組病例根據皮膚損害,疑診斷有誤,行PCR檢查及醋酸白試驗後修正診斷。區別
尖銳濕疣與假性濕疣應當互相區別。假性濕疣是近年來新認識的一種疾病。假性濕疣多見於青年婦女,未婚或已婚均可發生;發病年齡主要為18~40歲,發病率為16%~18%。臨床表現為1~2毫米大小的丘疹,淡紅色,群集不融合;表現光滑,形似魚子狀或絨毛狀,觸之有顆粒樣感;分布在小陰唇內側面或陰道前庭。一般沒有什麼自覺症狀或僅有輕度瘙癢感,臨床上容易與尖銳濕疣相混淆。尖銳濕疣多發生於外陰、陰道、尿道口、子宮頸及肛周,初為淡紅色或污灰色濕潤小丘疹,很快形成疣樣增殖,大小不等,可融合,形如菜花狀或雞冠樣等,有時有分泌物,並有臭味。臨床上鑑別時可用紗布或棉棒浸蘸5%醋酸溶液緊敷患處,2~5分鐘後觀察:如為尖銳濕疣,則局部變為白色,此為陽性反應;假性濕疣則為陰性反應,即不變色。如果局部有炎症時,可為假陽性反應,必要時可做病理檢查。
假性濕疣病因尚不明,一般認為是一種與發育異常有關的良性乳頭瘤。此病的發生與體內激素水平是否有關,尚待進一步研究。
尖銳濕疣潛伏期
HPV感染人體後能否發生尖銳濕疣與多種因素有關。尖銳濕疣的臨床表現主要有兩種:一種是出現可見的典型的尖銳濕疣損害,稱為尖銳濕疣顯性臨床表現即尖銳濕疣;另一種是無明顯可見的尖銳濕疣損害,但通過放大鏡觀察或經醋酸試驗後可觀察到顆粒狀損害,此稱為尖銳濕疣亞臨床表現。此外有學者將無顯性尖銳濕疣臨床表現和/或尖銳濕疣亞臨床表現而僅有HPV DNA檢查陽性者列入尖銳濕疣的臨床表現中,稱之為HPV潛伏感染,作者認為欠妥,應予糾正。
從HPV感染人皮膚黏膜後到尖銳濕疣損害出現需要一段時間,將這段時間稱為尖銳濕疣潛伏期。尖銳濕疣潛伏期的長短因人而異,有些人的潛伏期短,有些人的潛伏期則較長。據調查尖銳濕疣的潛伏期為3周到8個月,平均2.8個月。大多數臨床觀察報導不可能有外生殖器疣的表現,但有57%的患兒在2歲時診斷為喉乳頭瘤。作者曾見到1例男性尖銳濕疣患者之女性性伴在與其性交後2周陰道口長出尖銳濕疣損害,作者病例中的另一例男性患者是在與女性尖銳濕疣患者性交接觸1年半後才發病。此外,在作者的尖銳濕疣病例中能明確尖銳濕疣發病潛伏期的有476例,其中男性243例,女性233例。在男性中,潛伏期1個月者8例,2個月者58例,3個月者68例,4個月者69例,5個月者12例,6個月者17例,7個月者8例,12個月者2例,1年3個月者1例;在女性中,潛伏期1個月者24例,2個月者62例,3個月者65例,4個月者49例,5個月者15例,6個月者8例,7個月者3例,8個月者2例,9個月者1例,10個月者1例,11個月者2例,12個月者1例。從作者上述調查結果進一步證實尖銳濕疣潛伏期多在2個月,占73.38%。上述結果還表明潛伏期在男女性間有差異,如女性潛伏期多較短,男性潛伏期較女性增長。作者還觀察到男女性尖銳濕疣潛伏期與患者局部環境有明顯關係,如局部衛生差、潮濕、分泌物多者尖銳濕疣潛伏期短,反之則潛伏期略長。
臨床特點
潛伏期3周到8個月,平均3個月,多見於性活躍的青、中年男女,發病高峰年齡為20-25歲,病程平均在3-5個月的男女患者,在性接觸後不久即發病,而病程平均12個月的男性患者,其性接觸者可不發病。多數患者一般無症狀。損害大小及形狀不等。可僅為數個,亦可為多數針頭樣大的損害:在陰肛部可長成大的腫瘤樣物,有壓迫感;有惡臭味;有時小的濕疣可出現陰部痛癢不適,病人可出現尿血和排尿困難;直腸內尖銳濕疣可發生疼痛、便血,而直腸內大的濕疣則可引起里急後重感。
男性患者好發於包皮系帶、冠狀溝、包皮、尿道、陰莖、肛門周圍和陰囊。病初為淡紅或污紅色粟狀大小贅生物,性質柔軟,頂端稍尖,逐漸長大或增多。可發展成乳頭狀或囊狀,基底稍寬或有帶,表面有顆粒。在肛門部常增大,狀如菜花,表面濕潤或有出血,在顆粒間常積存有膿液,散發惡臭氣味,搔抓後可繼發感染。位於濕度較低乾燥部位的生殖器疣,損害常小而呈扁平疣狀。位於濕熱濕潤部位的疣常表現為絲狀或乳頭瘤狀,易融合成大的團塊。有嚴重肝病的患者濕疣可增大。妊娠可使濕疣復發或生長加快。臨床感染是指臨床上肉眼不能辨認的病變,但用3%-5%醋酸液局部外塗或濕敷5-10分鐘可在HPV感染區域發白,即所謂“醋酸白現象”。
診斷真假尖銳濕疣的實驗室方法
(1)細胞學檢查取陰道、子宮頸等部位的濕疣組織作成塗片,作帕氏染色。在塗片中可以見到兩種細胞,一種細胞的核周圍有暈環,它占據了細胞漿的大部分,而將細胞漿壓縮到邊緣呈濃縮狀,此種細胞稱為空泡化細胞,它來源於淺層的鱗狀上皮細胞;另一種細胞稱為角化不良細胞,可單個或成堆分布,胞漿呈橙紅色至淡黃色,核小而緻密。在尖銳濕疣病的的塗片中這兩種細胞常可混合存在。(2)組織病理變化主要為角化不全,棘層高度肥厚,乳頭瘤樣增生。粒層和棘層上部細胞有明顯的空泡形成。棘細胞基底細胞有相當數量之核分裂,頗似癌變,但細胞排裂規則,且增生上皮和真皮之間境界清楚。
預防
一、早發現早治療對於有性病接觸的朋友而言,要隨時注意生殖器有無異常變化,同時可進行有關的檢查,以便能早期發現、早期診斷、早期治療。
二、開展宣傳教育工作
這也是一個全社會的責任。宣傳教育工作要做到深入,普及到社會的個個階層,尤其是對於青少年更要引起重視,不論男女都要使其了解性病的有關知識,了解性病傳染途徑,傳染特點,了解性病對人類身心健康所造成的危害性。通過宣傳,提高公眾對性病的認識,增強人們對家庭和社會的責任感,增強人們的自我保護意識,最終達到人人潔身自愛,以減少尖銳濕疣等性病的感染機會。
三、嚴格自律,保持樂觀的心態
在該病尚未治癒之前,要嚴格控制私慾,不可發生性行為,以免傳染給他人。做到不要性交,不要在公共浴(泳)池洗澡、游泳,不要亂用他人物品,即使使是經過治療後尖銳濕疣損害已不存在,也應在相當一段時間內、至少在半年內還應堅持做到。若無尖銳濕疣損害,在性交時推薦使用保險套,以減少尖銳濕疣和HPV傳染的機會。
四、杜絕不潔性行為
對於性伴侶患有尖銳濕疣的朋友要對其做相關的檢查,查看有無感染。因為大多數尖銳濕疣患者的再感染與其性伴患尖銳濕疣和HPV感染有關,故要避免與其性接觸,以減少患者治療後再感染的機會。要使人們了解隨意性行為的安全性,改變性行為方式,從而減少患尖銳濕疣的危險。